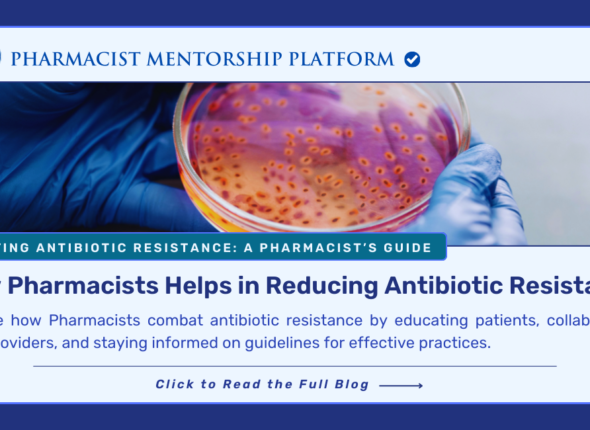
9

No products in the cart.
Blog
A Comprehensive Guide to BoneMarrow Transplantation
Bone marrow transplantation (BMT), or hematopoietic stem cell transplantation (HSCT), is a life-saving procedure used to treat severe...
Electrolyte Management: A Clinical Guide to Balance, Dosing, and Correction
A practical clinical guide to electrolyte balance, dosing, and safe correction of sodium, potassium, calcium, magnesium, and phosphorus...
Medication Decisions by AI? Know the Risks Before You Skip the Doctor
AI tools are reshaping healthcare, but can they safely replace doctors and pharmacists in medication decisions? Discover the...
6 Ways to Manage Dehydration This Summer!
Learn 6 simple yet powerful ways to stay hydrated and avoid dehydration this summer. Discover why hydration is...
The Importance of Healthcare Worker Safety: Protecting Pharmacists in Hematology and Oncology
Protecting pharmacists in hematology and oncology is vital. Learn the risks they face and explore safety practices to...
Prevalence of Gestational Diabetes in Metformin Treated and Non-Treated PCOS Women
Polycystic Ovary Syndrome (PCOS) increases the risk of developing Gestational Diabetes Mellitus (GDM) during pregnancy. In a recent...
What Is Mental Health? Key Importance, Major Issues, and Effective Prevention Tips
Mental health is essential for overall well-being, influencing how we think, feel, and act. This article explores the...
The Role of Pharmacists in Public Health: Making a Real Impact Every Day
Pharmacists play a vital role in public health by educating patients, promoting disease prevention, and actively engaging with...
How Pharmacists Can Help in Reducing Antibiotic Resistance
Pharmacists play a crucial role in combating antibiotic resistance by educating patients, ensuring responsible use, and collaborating with...
How E-Prescriptions Affect Community Pharmacies
E-prescriptions are transforming community pharmacies by making workflows faster, reducing errors, and enhancing patient care. Discover how pharmacists...